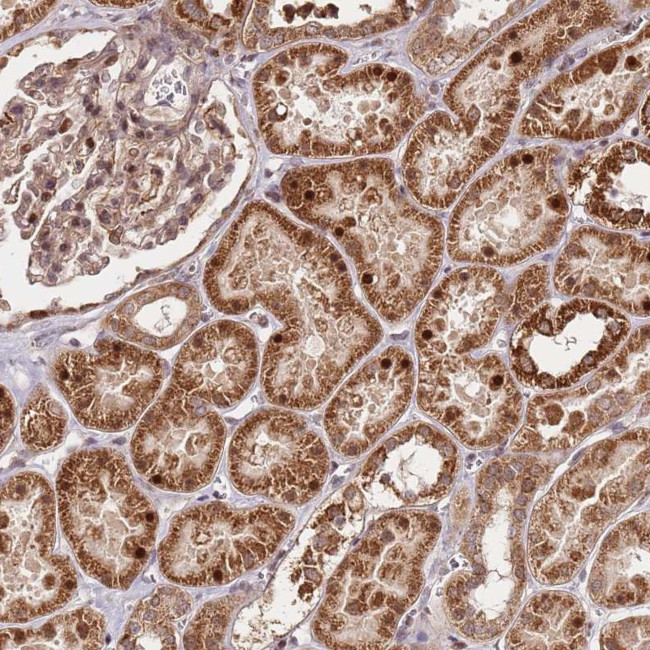
EDC3 Antibody in Immunohistochemistry (Paraffin) (IHC (P))

Search
Invitrogen
EDC3 Polyclonal Antibody
{{$productOrderCtrl.translations['antibody.pdp.commerceCard.promotion.promotions']}}
{{$productOrderCtrl.translations['antibody.pdp.commerceCard.promotion.viewpromo']}}
{{$productOrderCtrl.translations['antibody.pdp.commerceCard.promotion.promocode']}}: {{promo.promoCode}} {{promo.promoTitle}} {{promo.promoDescription}}. {{$productOrderCtrl.translations['antibody.pdp.commerceCard.promotion.learnmore']}}
产品信息
PA5-60649
种属反应
宿主/亚型
分类
类型
抗原
偶联物
形式
浓度
规格
纯化类型
保存液
内含物
保存条件
运输条件
RRID
产品详细信息
Immunogen sequence: LDCPENVFLR DQPWYKAAVA WANQNRAPVL SIDPPVHEVE QGIDAKWSLA LGLPLPLGEH AGRIYLCDIG IPQQVFQEVG INYHSPFGCK FVIPL
Highest antigen sequence identity to the following orthologs: Mouse - 98%, Rat - 97%.
靶标信息
This gene encodes a protein that is important in mRNA degradation. The encoded protein is a component of a decapping complex that promotes efficient removal of the monomethylguanosine (m7G) cap from mRNAs, as part of the 5' to 3' mRNA decay pathway. Mutations in this gene have been identified in human patients with an autosomal recessive form of intellectual disability.
仅用于科研。不用于诊断过程。未经明确授权不得转售。
篇参考文献 (0)
生物信息学
蛋白别名: enhancer of mRNA decapping 3 homolog; Enhancer of mRNA-decapping protein 3; LSM16 homolog; LSM16 homolog (EDC3, S. cerevisiae); unnamed protein product; yjeF domain containing; YjeF domain-containing protein 1; YjeF N-terminal domain-containing protein 2; YjeF_N2
基因别名: EDC3; hYjeF_N2-15q23; LSM16; MRT50; PP844; YJDC; YJEFN2
UniProt ID: (Human) Q96F86
Entrez Gene ID: (Human) 80153